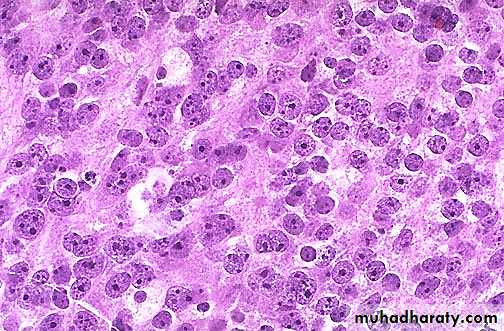

Male Genital Tract
A frequently performed operation for symptomatic nodular prostatic hyperplasia is a transurethral resection, which yields the small "chips" of rubbery prostatic tissue seen here.
Microscopically, benign prostatic hyperplasia can involve both glands and stroma, though the former is usually more prominent. Here, a large hyperplastic nodule of glands is seen.
At higher magnification, the enlarged prostate has glandular hyperplasia. The glands are well-differentiated and still have some intervening stroma. The small laminated pink concretions within the glandular lumens are known as corpora amylacea.
This is prostatic intraepithelial neoplasia (PIN), a precancerous cellular proliferation found in a single acinus or small group of prostatic acini. A normal prostatic gland is seen at the left for comparison with the acini showing PIN at the right. The finding of PIN suggests that prostatic adenocarcinoma may also be present.
These sections through a prostate removed via radical prostatectomy reveal irregular yellowish nodules, mostly in the posterior portion (seen here superiorly). This proved to be prostatic adenocarcinoma. Prostate glands containing adenocarcinoma are not necessarily enlarged. Adenocarcinoma may also coexist with hyperplasia.
At the right are normal prostatic glands containing scattered corpora amylacea. At the left is prostatic adenocarcinoma. Note how the glands of the carcinoma are small and crowded.
Prominent nucleoli are seen in the nuclei of this prostatic adenocarcinoma, which is a characteristic feature.
Here is a normal testis and adjacent structures. Identify the body of the testis, epididymis, and spermatic cord. Note the presence of two vestigial structures, the appendix testis and the appendix epididymis.
This is the microscopic appearance of normal testis. The seminiferous tubules have numerous germ cells. Sertoli cells are inconspicuous. Small dark oblong spermatozoa are seen in the center of the tubules.
There is focal atrophy of tubules seen here to the upper right. The most common reason for this is probably childhood infection with the mumps virus, which produces a patchy orchitis. However, it is unusual for this infection to cause enough atrophy to significantly affect the sperm count.
Here is a large hydrocele of the testis. Such hydroceles are fairly common. Clear fluid accumulates in a sac of tunica vaginalis lined by a serosa with a variety of inflammatory and neoplastic conditions. A hydrocele must be distinguished from a true testicular mass, and transillumination may help, because the hydrocele will transilluminate but a testicular mass will be opaque.
This testis has undergone infarction following testicular torsion. Torsion is an uncommon condition, but is a medical emergency. It occurs when twisting of the spermatic cord cuts off the venous drainage, leading to hemorrhagic infarction.
The mass lesion seen here in the testis is a seminoma. Germ cell neoplasms are the most common types of testicular neoplasm. They are most common in the 15 to 34 age group
Normal testis appears at the left, and seminoma is present at the right. Note the difference in size and staining quality of the neoplastic nests of cells compared to normal germ cells. Note the lymphoid stroma between the nests of seminoma.
Here is an embryonal carcinoma of the testis. There is a rim of normal testis superiorly. The tumor is soft and much more variegated than the seminoma, with red to tan to brown areas, including prominent hemorrhage and necrosis.
This is the histologic pattern of embryonal carcinoma. Sheets of blue cells are trying to form primitive tubules.
At the bottom is a focus of cartilage. Above this is a primitive mesenchymal stroma and to the left a focus of primitive cells most characteristic for embryonal carcinoma. This is embryonal carcinoma mixed with teratoma.